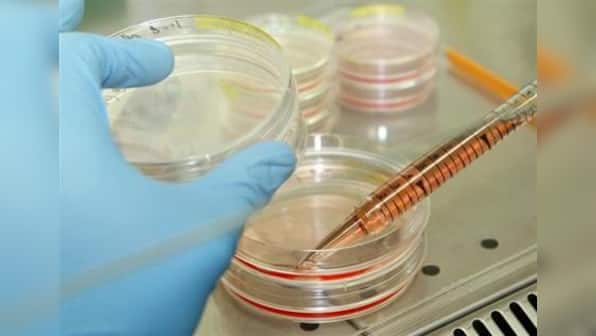

NEW YORK (Reuters) - After more than 15 years of failures by scientists around the world and one outright fraud, biologists have finally created human stem cells by the same technique that produced Dolly the cloned sheep in 1996: They transplanted genetic material from an adult cell into an egg whose own DNA had been removed.
The result is a harvest of human embryonic stem cells, the seemingly magic cells capable of morphing into any of the 200-plus kinds that make up a person.
The feat, reported on Wednesday in the journal Cell, could re-ignite the field of stem-cell medicine, which has been hobbled by technical challenges as well as ethical issues.
Until now, the most natural sources of human stem cells have been human embryos, whose use in research poses ethical quandaries. The technique announced on Wednesday, by scientists at Oregon Health & Science University and the Oregon National Primate Research Center, uses unfertilized human eggs.
Eliminating the need for human embryos could boost attempts to use stem cells and their progeny to replace cells damaged or destroyed in heart disease, Parkinson’s disease, multiple sclerosis, spinal cord injuries and other devastating conditions.
But the achievement could also revive fears of reproductive cloning, or producing genetic copies of living (or dead) individuals.
Even before the study was published, a British watchdog group called Human Genetics Alert protested the research.
Impact Shorts
More Shorts“Scientists have finally delivered the baby that would-be human cloners have been waiting for: a method for reliably creating cloned human embryos,” said Dr. David King, the group’s director. “This makes it imperative that we create an international legal ban on human cloning before any more research like this takes place. It is irresponsible in the extreme to have published this research.”
Among scientists, however, the accomplishment is being hailed as “a tour de force,” as stem cell biologist George Daley of the Harvard Stem Cell Institute put it. “This represents an unparalleled achievement. They succeeded where many other groups failed, including mine.”
The highest-profile failure was that of biologist Hwang Woo-suk of Seoul National University in South Korea. In 2005 he and his team made headlines across the globe when they claimed, in the journal Science, that they had created human embryonic stem cells via nuclear transfer, the same technique the Oregon scientists used. Hwang’s claim turned out to be a lie, making it one of the most infamous cases of scientific fraud in the last decade.
DOLLY THE SHEEP
If the Oregon achievement holds up and can be replicated by scientists in other labs, it would offer a third, and potentially superior, way of producing embryonic stem cells.
The field of stem cells took off in 1998, when scientists led by Jamie Thomson at the University of Wisconsin announced that they had harvested the cells from days-old human embryos, called blastocysts, obtained from fertility clinics.
The fact that the blastocysts are destroyed when their stem cells are removed ignited a furor from groups that believe life begins at conception. In 2001, President George W. Bush banned federal funding for research that would create more blastocysts, but stem cells already produced from them were fair game.
Those cell lines turned out to be fewer and of poorer quality than scientists had hoped. The next breakthrough came in 2007, when Shinya Yamanaka of Kyoto University produced human embryonic stem cells in a way that did not require eggs or embryos. He added four genes to adult cells, and the result was like turning back the calendar: The adult cells, which he called induced pluripotent (iPS) cells, showed all the properties of embryonic stem cells, an achievement for which Yamanaka shared last year’s Nobel prize in medicine.
“The whole scientific community jumped on the iPS bandwagon,” said Dr. Robert Lanza, chief scientific officer of Advanced Cell Technology (ACTC.OB).
That turned attention away from a third technique for producing embryonic stem cells: the method that created Dolly the sheep in 1996. Scientists in Scotland had started with a sheep oocyte (egg), removed its DNA and replaced it with DNA from a sheep mammary gland cell. They zapped the egg with electricity to make it grow and divide like a fertilized embryo. No sperm were necessary.
This technique is called somatic cell nuclear transfer (SCNT). If the embryo is implanted inside a surrogate mother, as the Dolly team did, the result is reproductive cloning, which has also been done for mice, cows and other animals. But if embryonic development is halted after five days or so, the result is stem cells genetically identical to the donor’s - and thus custom-made for therapies to treat degenerative diseases without fear of rejection by the patient’s immune system.
The Oregon scientists, led by Shoukhrat Mitalipov, used a variation of the Dolly technique. They carefully inserted an adult skin cell into a donated human egg whose DNA had been removed. The unfertilized eggs, stimulated by electric pulses to start dividing, developed to about the 150-cell stage.
The cells were all true embryonic stem cells; they have the “ability to convert just like normal embryonic stem cells, into several different cell types, including nerve cells, liver cells and heart cells,” said Mitalipov. “While there is much work to be done in developing safe and effective stem cell treatments, we believe this is a significant step forward in developing the cells that could be used in regenerative medicine.”
ODD EGGS
In succeeding with humans, the Oregon team toppled the dogma that there is something odd about human eggs or embryos, said stem cell expert Rudolf Jaenisch of the Whitehead Institute and Massachusetts Institute of Technology: “Published data said there was a difference in principle between humans and the mice and other animals that had been cloned, a difference that presented an insurmountable barrier to human cloning” for either reproduction or stem cells.
The Oregon team figured out how to get the egg to act as if it had been fertilized. The secret was to keep the eggs in the phase of their growth cycle called “metaphase,” which is when DNA aligns in the middle of the cell before the cell divides. The scientists got the best results when they grew the eggs in a little of a substance that tends to be abundant in labs: caffeine.
When conducting the same experiment with monkeys, the Oregon scientists stopped at the production of stem cells and never implanted the ball of cells into a surrogate mother. Mitalipov said reproductive cloning is “not our focus, nor do we believe our findings might be used by others” to do it with humans.
“Reproductive cloning hasn’t been advanced by this new paper,” agreed MIT’s Jaenisch. “If you implanted these embryos, which would be illegal, I think you would get the same results as in mice: Most of them die at birth, and the others encounter big troubles as they age.”
STEM CELL FACE-OFF
Now the question is whether embryonic stem cells produced with the Dolly method would be superior to those created with the turn-back-the-calendar iPS method.
Scientists have already found that iPS cells tend to age prematurely and die. They are also created with cancer-causing genes, which could make them dangerous to use therapeutically.
Another possible advantage of the embryonic stem cells produced by the Dolly method: It takes just days, compared with weeks for iPS cells.
“If you have a patient who needs , that can be an important difference,” said Natalie DeWitt of the California Institute for Regenerative Medicine.
On the other hand, the human eggs needed for the Dolly technique are in short supply and hard to obtain, notes MIT’s Jaenisch. (The Oregon team paid the women who donated eggs for their time and “discomfort.”) Although the Oregon team coaxed stem cells out of every egg they collected from one of the women, other labs might not be so efficient.
If the Dolly technique becomes a reliable source of embryonic stem cells, it might accelerate clinical trials of the cells, which have been slow to get going and disappointing.
In 2011, for instance, biotechnology firm Geron (GERN.O) halted a clinical trial that used embryonic stem cells to repair spinal cord injuries and said it was leaving the field.
The most promising human study is ACT’s. It is two years into clinical trials using stem cells derived from human embryos to treat two forms of blindness, including macular degeneration, with encouraging results. One patient’s vision went from 20/400 to 20/40, said Lanza. (Reporting by Sharon Begley; Editing by Michele Gershberg and Douglas Royalty)

)

)
)
)
)
)
)
)
)



